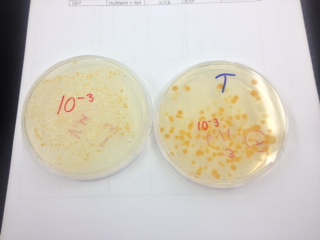

User:Valerie Moon/Notebook/Biology 210 at AU
February 19, 2014: Embryology Lab V.M. – Edited March 21, 2014
Introduction – Effects of Nicotine on Zebrafish
In this lab we will be testing the effects of Nicotine on larval zebrafish. We will have a control group and an experimental group, in which the only changed variable will be that the zebrafish are submerged in a solution of water and nicotine. We expect that the experimental group of zebrafish will be negatively impacted, particularly in terms of behavior, growth, and development. We will be conducting our experiment in a fashion similar to the methods described in Beatrice Parker and Victoria Connaughton’s study entitled “Effects of Nicotine on Growth and Development in Larval Zebrafish”. Similarly to this study, we will be recording data every few days, indicating the size, morphology, and behavior of the zebrafish.
The zebrafish is an ideal organism to test the effects of nicotine. This type of fish reaches adulthood in three months, reproduce often and quickly, and most importantly for our experiment, they constantly take in substances from the water they are submerged in. Therefore, we will be able to ensure the nicotine levels remain constant in the water, and the zebrafish will be continually absorbing the nicotine.
Purpose
Because the zebrafish is an ideal organism to study the effects of nicotine, we should be able to use our results as a model for other species, particularly the human species. Our findings should enable us to make inferences about the effect of nicotine in pregnant women, or at the very least suggest that the effect of nicotine in pregnant women is negative, and should be researched further.
Materials and Methods
Materials
1.) 40 zebrafish total
2.) deerpark water
3.) Nicotine solution (25 miligrams / liter)
4.) Dissecting microscope
5.) 3 petri dishes (with covers)
6.) Pipette
7.) 0.02% tricaine solution
8.) 4% formaldehyde
9.) Small vials to place fixed zebrafish into
10.) Depression slides
11.) Droppers
Methods – Day One:
1.) Make a hypothesis and prediction (our hypothesis is included in the introdcution)
2.) Select 40+ zebrafish and place them in a petri dish filled with deerpark water.
3.) Setup the control group. Add 25 mls of deerpark water to a petri dish labeled control and add 20 zebrafish eggs, using a dropper, from the 40+ collected (ensure that all 20 are living).
4.) Setup the experimental group. Add 25 mls of nicotine solution to a petri dish labeled experimental and add 20 zebrafish eggs, using a dropper, from the 40+ collected (ensure that all 20 are living).
5.) Make observations about 9 dependent variables. Record observations in a table.
1.) Hatching: count the number of eggs versus hatched zebrafish
2.) Viability: count number of dead zebrafish
3. Swimming and movement: make qualitative observations about activity
4. Timing: observe developmental stage and amount of yolk absorption
5. Observe eye pigmentation and eye movement
6. Observe body/tail pigmentation (use dissecting scope)
7. Observe the heart rate (measure if possible)
8. Observe structures (tail, fins, swim bladder)
9. Measure tail length, total length, and eye diameter is possible
6.) Leave the control and experimental petri dishes covered and in a safe place
Methods – Day Three
1.) Make observations about the 9 dependent variables listed above in day one. Record all measurements and observations in a table.
2.) Extract 10 ml of water from the control dish and use a pipette to replace with 15 ml of deerpark water.
3.) Extract 10 ml of nicotine solution for the experimental dish and use a pipette to replace with 15 ml of nicotine solution.
4.) Preserve any dead zebrafish. To preserve, place the dead zebrafish in 0.02% tricaine solution, then transfer to a vial of 4% formaldehyde. Label the vial
Methods – Day Six
1.) Make observations about the 9 dependent variables listed above in day one. Record all measurements and observations in a table.
2.) Extract 10 ml of water from the control dish and use a pipette to replace with 15 ml of deerpark water.
3.) Extract 10 ml of nicotine solution for the experimental dish and use a pipette to replace with 15 ml of nicotine solution.
4.) Preserve any dead zebrafish. To preserve, place the dead zebrafish in 0.02% tricaine solution, then transfer to a vial of 4% formaldehyde. Label the vial
Methods – Day Eight
1.) Extract 10 ml of water from the control dish and use a pipette to replace with 10 ml of deerpark water.
2.) Extract 10 ml of nicotine solution for the experimental dish and use a pipette to replace with 10 ml of nicotine solution.
3.) Make observations about the 9 dependent variables listed above in day one. Record all measurements and observations in a table.
4.) Place samples of zebrafish from both groups onto a depression slide and observe using a light microscope.
5.) Sacrifice and fix 3 zebrfish from control and 3 zebrafish from experimental. (Follow step from day three, step 4)
Methods – Day Eleven
1.) Make observations about the 9 dependent variables listed above in day one. Record all measurements and observations in a table.
2.) Use a pipette to add 10 ml of deerpark water to the control group. Do not take any water out.
3.) Use a pipette to add 10 ml of nicotine solution water to the experimental group. Do not extract any solution.
4.) Preserve any dead zebrafish. To preserve, place the dead zebrafish in 0.02% tricaine solution, then transfer to a vial of 4% formaldehyde. Label the vial
Methods – Day Sixteen (The final day of data collection)
1.) Make observations about the 9 dependent variables listed above in day one. Record all measurements and observations in a table.
2.) Observe previously fixed samples if necessary
2.) Place any living zebrafish from the control dish in a large dish filled with water.
3.) Place any living zebrafish from the experimental dish in a large dish filled with water.
4.) Preserve any dead zebrafish. To preserve, place the dead zebrafish in 0.02% tricaine solution, then transfer to a vial of 4% formaldehyde. Label the vial
Data and Observations
Below is the data that Vivian Zohery and myself compiled.
The above tables suggests that as the number of days increased, a number of subtle differences between the control and experimental group arose. These subtle differences included that the zebrafish from the experimental group appeared to have a slightly stunted growth, have less melanophores (lighter body pigmentation), and also had a slightly smaller eye diameter. As for behavioral differences, we did not notice any significant differences, but we may have had different conclusions about this if we had been able to make final observations on day 16.
Discussion
It should be noted that we were unable to collect data on the fourteenth day because of a snow day. Therefore, our final data collection day was the eleventh day. When we attempted to collect data on the sixteenth day, the zebrafish has all died except from one living in the control group, and one living in the experimental group. We noticed that the water level/nicotine solution level was very low, and we expect that the zebrafish died due to high temperatures, since there was the same number of dead zebrafish in the control group.
In addition, when collecting our data, we found in particularly difficult to collect data from the heart beat. Even when we utilized depression slides, we were unable to count the accurate bpm measurement. Therefore, we will be unable to discuss heart rate in our study, because our findings of this measurement were inconclusive. We also had difficulty distinguishing between the yolk and the swim bladder, so that depended variable may not be absolutely accurate.
Although we did not seem to find any overwhelming negative results of the nicotine, growth did seem to be slightly stunted, as well as the pigmentation. Our observational study, although cut short, suggests that nicotine plays a negative role in the development, and external features of the zebrafish. This finding suggests that further research should be performed to further provide evidence of this. For future research, using the zebrafish, research would be improved if data was collected ever day, if the zebrafish were placed in a more stable environment, and if they were submerged in perhaps a higher concentration of nicotine. Tests should also be performed perhaps on other fish species, to ensure that the negative impact of nicotine does not occur only within the zebrafish species. Then, with further evidence, the negative impacts of nicotine may be related to smoking pregnant women, and can provide specific reasons as to why it is detrimental to the developing human fetus.
February 26, 2014: Week 6 V.M.
Introduction – PCR Results Mini Lab
Refer to labs 2 and 3 for background information of this lab.
Purpose
The purpose of this lab is to analyze the PCR results we received from the lab on our transect samples we sent to be analyzed. We will use these results and compare them to the observations we made about the bacteria from our Hay Culture Infusion about gram-staining and cell morphology.
Materials and Methods
Refer to labs 2 and 3 for materials and methods.
Data and Observations
It should be noted that there was some confusion surrounding the labeling of everyone’s PCR samples. Our transect is transect # 5, but on our label we wrote # 3.
Below is a table of the results of our PCR reactions and the research I performed on the two bacteria.
Our previous observations: The two samples we took in class were to gram negative and gram positive. The first sample was from the normal nutrient plate. The bacteria colonies were orange, circular, smooth, flat, and entire. The cell itself was circular, tetrads, and cocci. This description seems to resemble to first bacteria from the PCR results. The other sample we tested in PCR was from the tetracycline plate. The colony was beige, circular, smooth, entire, and slightly raised. The cell itself was bacilli, not motile, diplobacilli, and spread out.
Conclusions
The results from our PCR reactions and our observations about the morphology, and gram stain of the bacteria we observed from our transect do not seem to match. I wonder if this is because the labels of everyone's data became confused. However, the photo of Chryseobacterium resembles the orange colony of bacteria we observed from our hay infusion culture.
February 12, 2014: Week 5 V.M. – Edited February 26, 2014
Introduction – Invertebrates
In today’s lab we became better acquainted with the animals of our transect, by observing the invertebrates we found, and others not from our transect, and by thinking about the vertebrates that may be present, even though we did not directly see any. As we know, an ecosystem is comprised of many abiotic and biotic components. The animals of the ecosystem play a vital role, and today we will begin to understand these roles.
Purpose
The purpose of today's lab is once again to further familiarize ourselves with our transect. However, since last week we paid particular attention to the plant life, this week we will be paying attention to the animal life. I hypothesize that our berlese funnel setup will show that we have a great number of small invertebrates living under the soil of our transect, perhaps small mites, beetles, spiders, and lots of other invertebrates.
Materials and Methods
Materials
1.) Dissecting microscope
2.) Roundworms, flatworms, and earthworms
3.) Petri dish
4.) Dichotomous key
5.) Berlese funnel
6.) Paper
7.) Writing utensil
Part One Methods
1.) Observe the roundworms, flatworms, and earthworms under a dissecting microscope
2.) Describe the body structures and movement of the worms, and think about how these two are connected.
Part Two Methods
1.) Transfer the preservative solution from the berlese setup into a petri dish
2.) Examine this under a microscope
3.) Observe any organisms in the petri dish under a microscope.
4.) Identify at least five organisms. Measure the length of each organism.
Part Three Methods
1.) Identify any vertebrates that may possibly inhabit the transect. Determine their classification, and explain what biotic and abiotic elements of the transect would benefit the animal.
2.) Construct a food web including the organisms you have discovered in your transect.
Data and Observations
Distinguishing between Acoelomates, Pseudocoelomates, and coelomates:
1. – Planaria – Flatworm (Acoelomate)
-Flat, wide, and long
-Sluggish movement, similar to how an inchworm moves, by inching along. Because they are wide and flat it is probably easier to move by inching rather than side to side.
2. – Nematode – Roundworm (Pseudocoelomate)
-Long, thin, and circular
-Wiggle movement, side to side. Because they are so thin, it is easier for them to weave because their body will not get in the way, like it would if they were wider.
3. – Annelida – Earthworm (Coelomate)
-Long, thicker than nematodes, with many rings
-Accordion-like movement. With the rings, the earthworm is able to scrunch it’s body together, and then push itself together.
Arthropod Activity:
Note: The list from top to bottom read: Arachnids, Crustaceans, Millipedes, Centipedes, Insects.
Berlese Funnel Data:
Unfortunately, our berlese funnel setup did not collect any invertebrates. We don’t believe that this is an indication that our transect doesn’t house any invertebrates. Instead, we suspect that our berlese setup failed to collect any invertebrates because we did not place leaves at the bottom of the funnel. Instead, we poured the contents of the soft soil into the funnel without placing the leaves at the bottom, and so the invertebrates may not have been able to sift through to the bottle.
Because our berlese funnel setup did not collect any invertebrates, we observed a number of invertebrates collected form West Virginia.
Below is a table of the invertebrates we examined from West Virginia:
I looked at a number of sources to find the length of these organisms, and the numbers varied greatly, so I made estimates based on the numbers I read.
Possible vertebrates that may inhabit our transect:
5 groups of vertebrates: Reptiles, Amphibians, Mammals, Birds, & Fish
I believe that the majority of vertebrates from our transect will be from the mammal or bird groups, however, there may also be some reptiles and amphibians, but no fish. Below are five species of vertebrates that i would expect to see in our transect:
1. Eastern Grey Squirrel (Sciurus carolinensis) – mammal
Classification: Pylum: Chordata, Class: Mammalia, Order: Rodentia, Family: Sciuridae, Genus: Sciurus
These squirrels are incredibly prevalent throughout DC. In the summer this squirrel constructs nests in trees, and so the Oak tree close to our transect could act as a home, an then the squirrel may come down from the tree to scavenge for food in our transect, looking for acorns, seeds, and perhaps some types of fungi that may be present.
2. Red-Backed Salamander (Plethondon cinereus) – amphibian
Classification: Phylum: Chordata, Class: Amphibia, Order: Caudata, Family: Plethodontidae, Genus: Plethondon
This is one of the more common salamanders in the DC area. They are sometimes found under stones and logs in damp places. These salamanders may be attracted to the soft and damp soil of our transect, where they could find refuge hiding under damp leaves. In addition, these salamanders eat arachnids, worms, and insects, and so they would have plenty of a food source in the soft soil of our transect.
3. Carolina Chickadee (Poecile carolinensis) – bird
Classification: Phylum: Chordata, Class: Aves, Order: Passeriformes, Family: Paridae, Genus: Poecile
The Carolina Chickadee are found in the DC area year round. This sepcies of bird nests in holes of trees, and then scavenges for small insects, which they may find in our transect.
4. Ruby-throated Hummingbird (Archilochus colubris) – bird
Classification: Phylum: Chordata, Class: Aves, Order: Apodiformes, Family: Trochilidae, Genus: Archilochus
This Hummingbird resides in the DC area during the summer. The hummingbird feeds off of nectar from flowers, and so perhaps the hummingbird would be attracted to our transect when the roses on the rose bush are in bloom. In addition, this hummingbird also eats small insects, like the ones found in our transect.
5. The Eastern Garter Snake (Thamnophis sirtalis sirtalis)
Classification: Phylum: Chordata, Class: Reptilia, Order: Squamata, Family: Colubridae, Genus: Thamnophis
It is possible that this snake could find itself in our transect because it is found in nearly every type of habitat in the DC area. They are not picky eaters, and so they may eat small rodents and mammals, or smaller mammal like worms, salamanders, and frogs. Therefore, it is possible they may find food in our transect , which being able to hide themselves under the rose bushes.
With all of these vertebrates, plants, and invertebrates in mind, below is a food web of the transect:
Conclusions
After the past few weeks, we have comes to see that there are a number of abiotic and biotic elements in our transect, and there is a delicate relationship between these elements. Last week we learned about the plants in our transect, and this week we learned about the animals. The animals rely on the plants for for and shelter, and the plants also rely on the animals. There is also a relationship between the different species of animals in our transect. Some animals act as decomposers to recycle dead plant and animal material, while other animals prey upon the smaller animals. From the food web, and the information we learned this week and last week, it is clear that all the elements of the transect rely on each other in some form.
References
I found the information on these 5 DC-native species from: http://metro-naturalist.com/Animals/Fauna_Menu.html
Classification of garter snake: http://www.arkive.org/common-garter-snake/thamnophis-sirtalis/
Classification of hummingbird: http://www.holoweb.com/cannon/ruby.htm
Classification of chickadee: http://animaldiversity.ummz.umich.edu/accounts/Parus_carolinensis/
Classification of salamander: http://www.iucnredlist.org/details/59334/0
Classification of squirrel: http://animaldiversity.ummz.umich.edu/accounts/Sciurus_carolinensis/classification/
February 5, 2014: Week 4 V.M. – Edited February 26, 2014
Introduction – Characteristics, diversity, and importance of plants & fungi
In today’s lab we focused on the plant and fungi specimens in our transect. After collecting our samples we noted distinguishing characteristics. We paid particular attention to the vascularization of the plants we collected, as well as specialization and the manner of reproduction the plants use. All of these characteristics make the plants specific to our transect able to thrive in the ecosystem. In addition, after collecting all of our data, we will begin to see the role that plants and fungi may play in our small transect.
Purpose
The purpose of today’s lab is further familiarize ourselves with the living components of our transect. Because our transect is very small, I'm not sure how much plant life will be present, but I expect to see at the minimum, grass and rose bushes, but we will see what else there is.
Materials and Methods
Part One Materials:
1.) 2 bags
2.) Petri dish to use as a shovel
Part One Methods:
1.) Bring two empty bags to the transect (make sure there are no holes)
2.) In the first bag, collect about 500g of leaf litter sample (dead leaves, soft soil)
3.) In the second bag, take samples of 5 plants in the transect. In this bag, also put any seeds, pine cones, etc.
4.) Take photos of plants if necessary
5.) Identify the plants in the transect using a guide
6.) Describe the vascularization of the plants present
7.) Observe the arrangement, and other characteristics of the leaves collected from the transect
8.) Identify and observe the seeds from the transect
9.) Use a dissecting microscope to make any further observations about the plant samples
10.) Observe the fungi previously collected on the agar plates. Look at these samples under a dissecting microscope.
11.) Draw and describe the fungi
Part Two Materials:
1.) 25 ml of 50:50 ethanol/water solution
2.) small bottle
3.) screening material
4.) funnel
5.) tape
6.) lamp
7.) stand with a clamp
Part Two Methods:
1.) Pour 25 ml of 50:50 ethanol/water solution into the small bottle. There should be a little bit of room left at the top of the bottle.
2.) Tape a piece of screening material to the bottom of the funnel
3.) Place the small bottle on the stand. Clamp the funnel so that it rest slightly above the opening of the bottle.
4.) Pour the leaf litter into the funnel, and fill the funnel to the top. (The leaves should be placed at the bottom of the funnel, covering the screen).
5.) Place a light over the funnel and then cover everything with foil.
Data and Observations
We collected 5 samples of plants from our transect. Below is a photo of our 5 collected plants, and their names:
Sample 1: Leaf from a black oak tree
Sample 2: Leaf and seeds from a rose bush
Sample 3: A clump of grass
Sample 4: Clover
Sample 5: Moss
Below is a table that we created, depicting the vascularization, specialization, and reproduction/type of seed.
Below is a map of our transect depicting where our samples were extracted from:
We observed a sample of fungi in a petri dish under a dissecting microscope. We determined the sample was, indeed, fungi because we could observe the black sporangia made of hyphae. Also, on the underside of the petri dish, the rhizoids are visible, which are hyphae that have grown into the agar like roots.
Below is a drawing of the fungi we observed: The black-bread mold (Rhizopus stolonifer)
Conclusions
I was surprised by the number of plant specimens in our transect. At first glance, I though we would have trouble collecting at least 5 different samples, but we easily could have collected more. In addition, the samples we collected were diverse. Some plants were large and some were small, some where vascular and some weren't, and some had seeds while others didn't. Upon researching the different plants, and studying them in lab, it is clear that although the 5 plant species we observed were different from one another, they each had particular characteristics that enable them to thrive in their small ecosystem.
January 29, 2014: Week 3 V.M. - Edited February 16, 2014
Introduction - Characteristics of Bacteria and Antibiotic Resistance
In today's lab we once again observed our hay culture infusion and made note of any differences. Then, we then moved on to observe the petri dishes we setup last week, and we observed the differences/morphology between the plates with/without antibiotic. Next, to further observe cell morphology we observed four samples of agar/antibiotic and agar plates. Finally, we prepared gram stains of the four samples.
Purpose
The purpose of conducting these different procedures in today's lab is to familiarize ourselves with the characteristics of bacteria, and observe antibiotic resistance, using samples from our transect.
Materials and Methods
Part One Materials:
1.) Hay Culture Infusion
2.) Last week's prepared petri dishes
Part One Procedure:
1.) Record observation about Hay Culture Infusion. Note any changes in appearance, smell, etc.
2.) Count the number of colonies on each agar plate
Part Two Materials:
1.) Last week's prepared petri dishes
Part Two Procedure:
1.) Observe distinguishing characteristics between colony types on plates with and without the antibiotic. Think about what this indicates.
2.) Observe/determine what is the effect of tetracycline on the total number of bacteria and fungi? How many species of bacteria are unaffected by this antibiotic?
3.) Research how tetracycline works, and research which bacteria are sensitive to it.
Part Three Materials:
1.) Sterilized loop
2.) Last week's prepared petri dishes
3.) Slides
4.) Cover slips
5.) Microscope
6.) Bunsen burner
7.) Wax pencil
8.) Staining tray
9.) Crystal violet
10.)Wash bottle filled with water
11.) Gram's iodine
12.) 95% alcohol
13.) Safranin stain
14.) Paper towel
15.) Oil
Part Three Procedure:
1.) Make a wet mount for two samples from the nutrient agar plates, and two from the nutrient agar plus tetracycline plates
-Sterilize a loop over a flame
-Use the loop to scrape up a tiny amount of growth from the agar plate
-Mix the sample into a drop of water on a slide
-Cover with a coverslip
-Observe under a microscope (first observe at 10x then at 40x)
-Determine observed cell shapes and whether they are motile
-Draw each organism observed
2.) Gram stain the four preps
-Label the slides with a sharpie, and use a wax pencil to circle on the underside of the slide where the specimen is.
-Pass each slide through a flame a few times with the bacterial smear slide up.
-Place the slides on a staining tray, and cover the slides with crystal violet for 1 minute.
-Rinse the stain off using a wash bottle.
-Cover the slide with Gram's iodine mordant for 1 minute. Then rinse gently.
-To decolorize, flood the slide with 95% alcohol for approximately 20 seconds. Then rinse gently.
-Use a paper towel to blot excess water, then allow the slides to air dry.
-Observe the slide at 40X
-Write down observations and draw sketches
3.) Prepare PCR for DNA sequence identification next week
-Choose two samples, one from plate with tetracycline, and one without the antibiotic.
-Mix a small amount of the colony in 100 microliters of sterile distilled water.
-Heat the tube of sample and water in a heating block for 10 minutes.
-Spin the sample for 1 minutes at 13.6K rpm ion microcentrifuge.
-Add 23 microliters of mastermix with forward and reverse primers to the PCR bead in the small tube. Mix well and carefully.
-Add 2 microliters of the bacteria DNA sample (out of the microcentrifuge) to the small tube with PCR bead.
-Place this tube into the PCR machine after mixing the tube carefully.
Data and Observations
Observations of Hay Culture Infusion
-Water level receded
-Water seems to have become clearer - you can look through the top of the water and see the bottom of the jar/the bottom layer of sediment
-Less of an odor (only very slightly)
-I suspect that the water level receded due to evaporation, and perhaps the culture became clearer because the sediment all fell to the bottom of the jar.
Observations of Petri Dishes
We observed that there was much more bacterial growth on the agar plus tetracycline plates, perhaps this is because the bacteria from our hay culture infusion happen to have antibiotic resistance. We also observed that there was fungi present on the the 10^-9 plate (without Tetracycline) and the 10^-7 and 10^-5 plates with Tetracycline. Also, all colonies appeared circular, but the two variations we found appeared to be either orange or beige in color.
We made note of the petri dishes that housed bacterial colonies, and were surprised that not all of the petri dishes had bacteria. We expected the more diluted samples to have less bacteria and the less diluted samples to have more colonies, but our observations did not reflect this prediction, perhaps because of an error in how we spread the samples on the agar, or how we conducted our dilutions. The following table represents our observations of the colonies present.
Comparing the 10^-3 plate and the T10^-3 plates, both plates have growth from the orange and beige types of bacteria. However, on the T10^-3 plate, the two types of bacteria seemed to thrive more and grew to become larger. However, in comparing the two types of bacteria on the T10^-3 plate, the orange bacteria colonies seemed to thrive more than the beige and became larger. In addition, all colonies, both orange and beige appear to be circular. Below are photos taken of the two plates in comparison. Therefore, we found that our two different types of bacteria colonies are unaffected by Tetracycline.
We made the following table about our three samples of gram stains to describe the colonies, and whether they are gram positive or negative.
We made the following diagrams of our colonies.
Conclusion
In this lab, we found that not only bacteria colonies formed on some of our agar plates (the normal agar plates, and the ones mixed with Tetracycline) but also fungi formed on some of these plates. We observed the colony morphology, and used a gram stain to determine which were gram positive and which were gram negative, and found that out of our three samples, the two from normal agar plates were gram positive, and the sample from the agar plate with tetracycline was gram negative. After doing some research into how Tetracycline functions, I found that this antibiotic inhibits the bacteria's ability to produce essential proteins to its survival. Therefore, this antibiotic prevents the bacteria from spreading. In next week's lab we will conduct gel electrophoresis on our PCR products.
Information about Tetracycline taken from http://www.netdoctor.co.uk/sex-and-relationships/medicines/tetracycline-tablets.html
2/6/14, lab 1 notes
Great work! Some notes:
-Make sure each lab entry is signed with initials
-Make sure photos are included by Sunday
-Start working on building a map of your transect to detail your land and where your samples are taken from. We will talk about this more Wednesday
Great job! AP
January 22, 2014: Week 2 V.M.- Edited February 9, 2014
Introduction - Hay Culture Infusion and Preparing Serial Dilutions
In today's lab we observed the Hay Infusion cultures that we set up in last weeks lab, in order to explore possible organisms in the different niches of our ecosystem. After observing out Hay Culture Infusion, we setup 100-fold dilutions of the culture spread these on agar petri dishes. We hope that next week when we observe our petri dishes that there will be prokaryotic organism and maybe some fungi present.
Purpose
The purpose of setting up and observing the Hay Culture Infusion this week is to observe the carrying capacity and the organisms present in the different niches of our ecosystem. The second step of today's lab was to set up agar petri dishes with dilutions of culture in the hopes that next week we will observe prokaryotic organisms and fungi. We hypothesize that next week we will see life in our petri dishes and we predict that we will see the most dense amount of prokaryotic/fungal growth on the less diluted petri dishes we created.
Materials and Methods
Part One Materials:
1.) Paper
2.) Writing utensil
3.) The Hay Culture Infusion
4.) Dropper
5.) Cover slide
6.) Slide
7.) Dichotomous key
8.) Microscope
Part One Procedure:
1.) Carefully bring the Hay Culture Infusion to station
2.) Make observations about the culture (i.e. smell, appearance, visible life)
3.) Take a few samples from the culture from different niches
4.) Note where the samples were extracted from in the culture
5.) Use dropper to place a small sample of the culture onto a slide, then cover with a coverslip
6.) Repeat step 5 for samples from at least 2 separate niches
7.) Observe samples under a microscope
8.) Draw pictures of observed organisms
9.) Using dichotomous key, attempt to identify the organisms
10.) Attempt to make other characterizations about the observed organisms
11.) Measure/record size of the organisms
Part Two Materials:"
1.) Four tubes of 10 ml sterile broth (make sure they're labeled 2, 4, 6, 8)
2.) Micropipeter set at 100 microliters (and tips for micropipeter)
3.) Four nutrient agar petri dishes
4.) Three agar plus tetracycline petri dishes
5.) Hay Infusion Culture
6.) Paper
7.) Writing utensil
Part Two Procedure:"
1.) Label the petri dishes with group initials, T (pm the tetracycline dishes), and the correct dilution on each plate
2.) Swirl the Hay Infusion Culture
3.) Take 100 microliters from the culture and aseptically add this sample to the 10 ml of broth in tube labeled 2 (for a 1:11 dilution)
4.) Swirl the tube well
5.) Take 100 micro liters of broth from tube 2 and add this to tube 4 (dilution of 1:10,000). Repeat this step twice again for tube 6 and tube 8
6.) Take 100 micro liters from tube 2 and aspectically spread onto the agar plate labeled 10^-3, and tetracycline agar plate also labeled 10^-3
7.) Take 100 micro liters from tube 4 and aspectically spread onto the agar plate labeled 10^-5, and tetracycline agar plate also labeled 10^-5
8.) Take 100 micro liters from tube 6 and aspectically spread onto the agar plate labeled 10^-7, and tetracycline agar plate also labeled 10^-7
9.) Take 100 micro liters from tube 8 and aspectically spread onto the agar plate labeled 10^-9
10.) Leave the petri dishes for a week to incubate at room temperature
Data and Observations
Hay Culture Infusion Observations:
-Murky water
-Dirt has settled on bottom
-Grass resting in middle
-White specks on top
-Layer of gray film on surface of water
-Tiny piece of fuzzy mold on piece of grass sticking out of the water
-Distinct and unpleasant odor
Samples - Extracted from Hay Infusion Culture:
We extracted two samples for observation. The first sample was extracted from the top of the water where we observed white speckles that had developed. The second sample, we extracted from the very bottom of the jar where the dirt and other vegetation lay. We hoped that these two different areas would house organisms from different niches. The water at the top could possibly house organisms that require more light, while the organisms at the bottom may not require light but may require nutrients from the vegetation.
Top of culture:
Organism 1 observed at 10x
-7 ocular spaces = 70 micrometers
-Seems to glide/spin and does not change shape
Organism 2 observed at 10x
-6 ocular spaces = 60 micrometers
-Moving very little
Organism 3 observed at 10x
-3 ocular spaces = 30 micrometers
-Very active and bouncing around
Bottom of culture:
Organism 4 observed at 10x
-2 ocular spaces = 20 micrometers
-Very agile, bouncing around
I did not come across as many organisms as I was expecting to find, and some of the organisms seemed to resemble one another, although they differed in size. I’m not sure if they are different organisms because of the differences in size, or if they are the same organisms at different maturity levels, and that is why they differ in size. (Ex: organisms 1, 3, and 4). This factor made it difficult to identify the organisms with the dichotomous key, and I did not come to conclusion about the organisms' identities.
The majority of organism I observed were motile, meaning that they were able to meet the needs of life by searching for nutrients, moving to shelter when in need, and moving to/from away whatever necessary.
Thoughts about Hay Culture Infusion:
Because we were observing organisms of different niches, it is important to think about the selective pressures that could possibly affect the composition of our sample. I believe that the selective pressures of our sample could include food availability, and availability of light. In addition, if I were to observe the hay infusion culture in two months, I would expect to see more mold growth. I would also expect to see more organism activity as the current organisms reproduced.
Conclusion
In today's lab we observed a number of different organisms taken from our Hay Culture Infusion. I did not seem to notice any distinguishing characteristics of the organisms from the different niches (samples from the top/bottom of the jar). However, we were able to observe the organisms we did find, and observe that there were all motile. In next week's lab we will observe the petri dishes that we set up today, and I expect to see prokaryotic growth, and hopefully some fungi as well.
Figures
Figure 1:
January 15, 2014: Week 1 V.M.
Introduction - First observations of transect
In this study we will be observing a transect of land on the American University campus in order to better understand how all the biotic and abiotic elements coexist and create a functioning ecosystem. Although the dimensions of our transect is 20 by 20 feet, this bit of land is still considered its own ecosystem, and over the coming weeks we will take the time to understand what we can about this small ecosystem.
Purpose
The purpose of today's lab is to become better acquainted with our small ecosystem and to observe the abiotic and biotic elements, as well as take notice of anything of interest. At this point, we do not have any hypothesis or predictions of interest, although we are familiar with the AU campus, we have an idea of what biotic and abiotic characteristics will be present.
Materials and Methods
Materials:
1.) paper
2.) writing utensil
3.) sterile 50 ml conical tube
4.) 500 ml of deerpark water
5.) .1g of dried milk, and a jar.
Procedure:
1.) Ensure that the transect's borders are marked with 4 popsicle sticks.
2.) Record the general characteristics of the transect, including the location, topography, and anything else important.
3.) Record the biotic and abiotic components.
4.) Use the 50 ml conical tube to collect a sample of the transect. We selected a sample including both soil and vegetation.
5.) With this sample, create a hay infusion culture. Begin by weighing 10-12 g of the sample.
6.) Place the 10-12 g of the transect sample into the plastic jar with the 500 ml of deerpark water.
7.) Add .1 g of dried milk into the jar and mix everything together gently for about 10 seconds.
8.) Label the jar with group members' names.
9.) Leave the jar in the back of the lab room in a safe spot.
Data and Observations
Location: Center of quad (center of footpath through the middle of the quad, and part of the adjacent lawn)
Topography/general characteristics: The transect includes grass, concrete, soil, stone, and some vegetation. It is completely flat, level, open and not protected by any trees or other forms of shelter.
Abiotic characteristics include: concrete, stone, soil
Biotic characteristics include: rose bushes, grass, unidentified green vegetation
Conclusion
All of our observations of the characteristics of our transect indicate that our ecosystem is somewhat diverse, regardless of its size. We were able to visibly see a number of biotic and abiotic characteristics, but with further research I feel confident that we will also discover a number of organisms that are not visible to the human eye. After setting up our hay infusion this week, the following week we may be able to draw some conclusions about our transect from observing the hay infusion culture, and the week after that we should be able to observe some samples of the hay infusion culture under a microscope and observe any organisms present.
January 22, 2014 Entered username and text successfully V.M.Excellent! MB